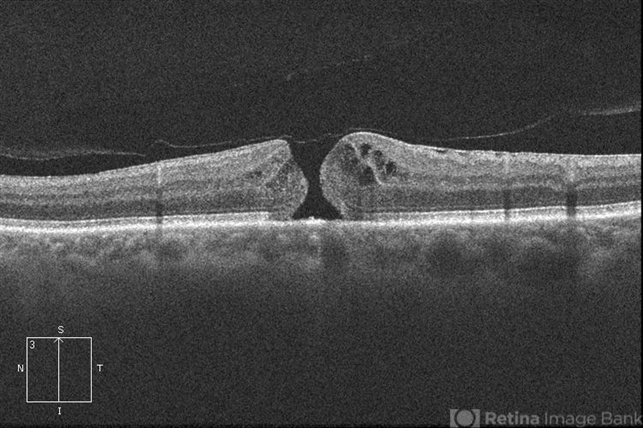

-
 By Peter K. Kaiser, MD FASRS
By Peter K. Kaiser, MD FASRS
Case Western Reserve University School of Medicine - Uploaded on Jul 3, 2012.
- Last modified by Jennifer Hicks on Aug 20, 2012.
- Rating
- Appears in
- Miscellaneous
- Condition/keywords
- macular hole
- Imaging device
-
Fundus camera
Cirrus

Initializing download.
Initializing download.










